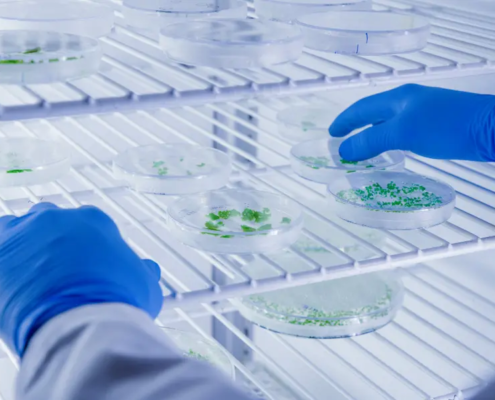
Monitoramento de temperatura na saúde

Registre os dados com confiabilidade de forma simples e prática.
Serviço de Excelência
Oferecemos um sistema integrado e abrangente para monitoramento de temperatura e umidade, garantindo mais segurança e eficiência para o seu processo.
A solução completa em monitoramento
Somos a referência em monitoramento de temperatura e umidade
Depoimentos dos Clientes
Hemepar
Acho o sistema muito fácil de trabalhar. Tanto para manutenção das temperaturas como para realização das audições. Sempre que precisamos de suporte técnico, somos prontamente atendidos. Parabéns!
OncoMed – Belo Horizonte
Com o monitoramento contínuo da temperatura e umidade conseguimos preservar medicamentos oncológicos dentro dos parâmetros adequados para uso no tratamento dos pacientes.
Catarinense Pharma
No ramo farmacêutico o controle de temperatura e umidade é algo crucial na qualidade da fabricação dos medicamentos. Um exemplo que o sistema remoto da Sensorweb foi eficaz e evitou perda de produção: Em uma parada por falha em um equipamento de tratamento de ar ambiente, onde em questão de minutos acusou um alerta e conseguimos restabelecer a máquina antes que chegasse no limite permitido no local de fabricação.
Fique por dentro dos nossos conteúdos!
Conservação de pesquisas na saúde: um caso de perdas evitadas com a solução Sensorweb
Estas notícias comprovam o resultado do investimento realizado na solução Sensorweb, ao evitar perdas de materiais em pesquisas na saúde com custos inestimáveis, como foi o caso do Dr. Guilherme Silveira do Instituto Carlos Chagas - FIOCRUZ.
Monitore agora a sua empresa!
Estamos aqui para solucionar. Preencha o formulário para que possamos entender suas necessidades e oferecer a solução mais adequada.













